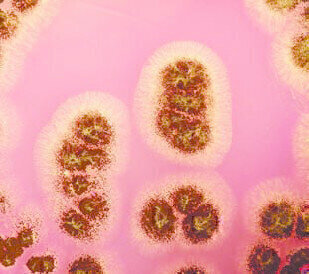
Tackling Fungal Food Spoilage

Laboratory products
Tackling Fungal Food Spoilage
Dec 03 2010
Lab M has added two new products to its expanding portfolio of specialist culture media for the isolation of yeasts and moulds from foodstuffs: Dichloran Rose Bengal Chloramphenicol Agar (ISO) and Dichloran 18% Glycerol Agar (ISO). Importantly, the new media comply fully with the requirements of ISO 21527- 1:2008 and ISO 21527-2:2008 respectively, standards that relate to the enumeration of yeasts and moulds in food and animal feeding stuff. Both products are supplied dehydrated as complete formulations that are ready to prepare without the need for any additional supplementation.
Widespread in nature, yeasts and moulds pose a contamination risk to foodstuffs during processing, packaging and storage. When creating media for their isolation and culture it is essential to balance the growth of selected organisms with a degree of control, in order to prevent overgrowth and enable efficient colony counting. The incorporation of the antifungal agent dichloran in the new media restricts the spreading of mucoraceous fungi and controls the colony size of other genera.
Dichloran Rose Bengal Chloramphenicol Agar (ISO) (DRBC Agar) is designed for the enumeration of viable yeasts and moulds in products with a water activity above 0.95. It is prepared according to ISO 21527-1:2008 and complies with Bacteriological Analytical Manual (BAM) and American Public Health Association (APHA) methods. In addition to glucose, dichloran and the anti-bacterial chloramphenicol, the medium incorporates Rose Bengal, which both helps limit colony size and is selective against bacteria.
Dichloran 18% Glycerol Agar (DG18 Agar) is for the enumeration of viable osmophilic yeasts and xerophilic moulds in food or animal feed products that have a water activity of 0.95 or less. The reduced water activity in this medium is achieved through the addition of glycerol at approximately 18%, the importance being that many yeast and moulds require a low water activity to enhance growth and colony development. Prepared according to ISO 21527-2:2008 DG18 is also and compliant with methods set out in the BAM.
Digital Edition
Lab Asia Dec 2025
December 2025
Chromatography Articles- Cutting-edge sample preparation tools help laboratories to stay ahead of the curveMass Spectrometry & Spectroscopy Articles- Unlocking the complexity of metabolomics: Pushi...
View all digital editions
Events
Jan 21 2026 Tokyo, Japan
Jan 28 2026 Tokyo, Japan
Jan 29 2026 New Delhi, India
Feb 07 2026 Boston, MA, USA
Asia Pharma Expo/Asia Lab Expo
Feb 12 2026 Dhaka, Bangladesh